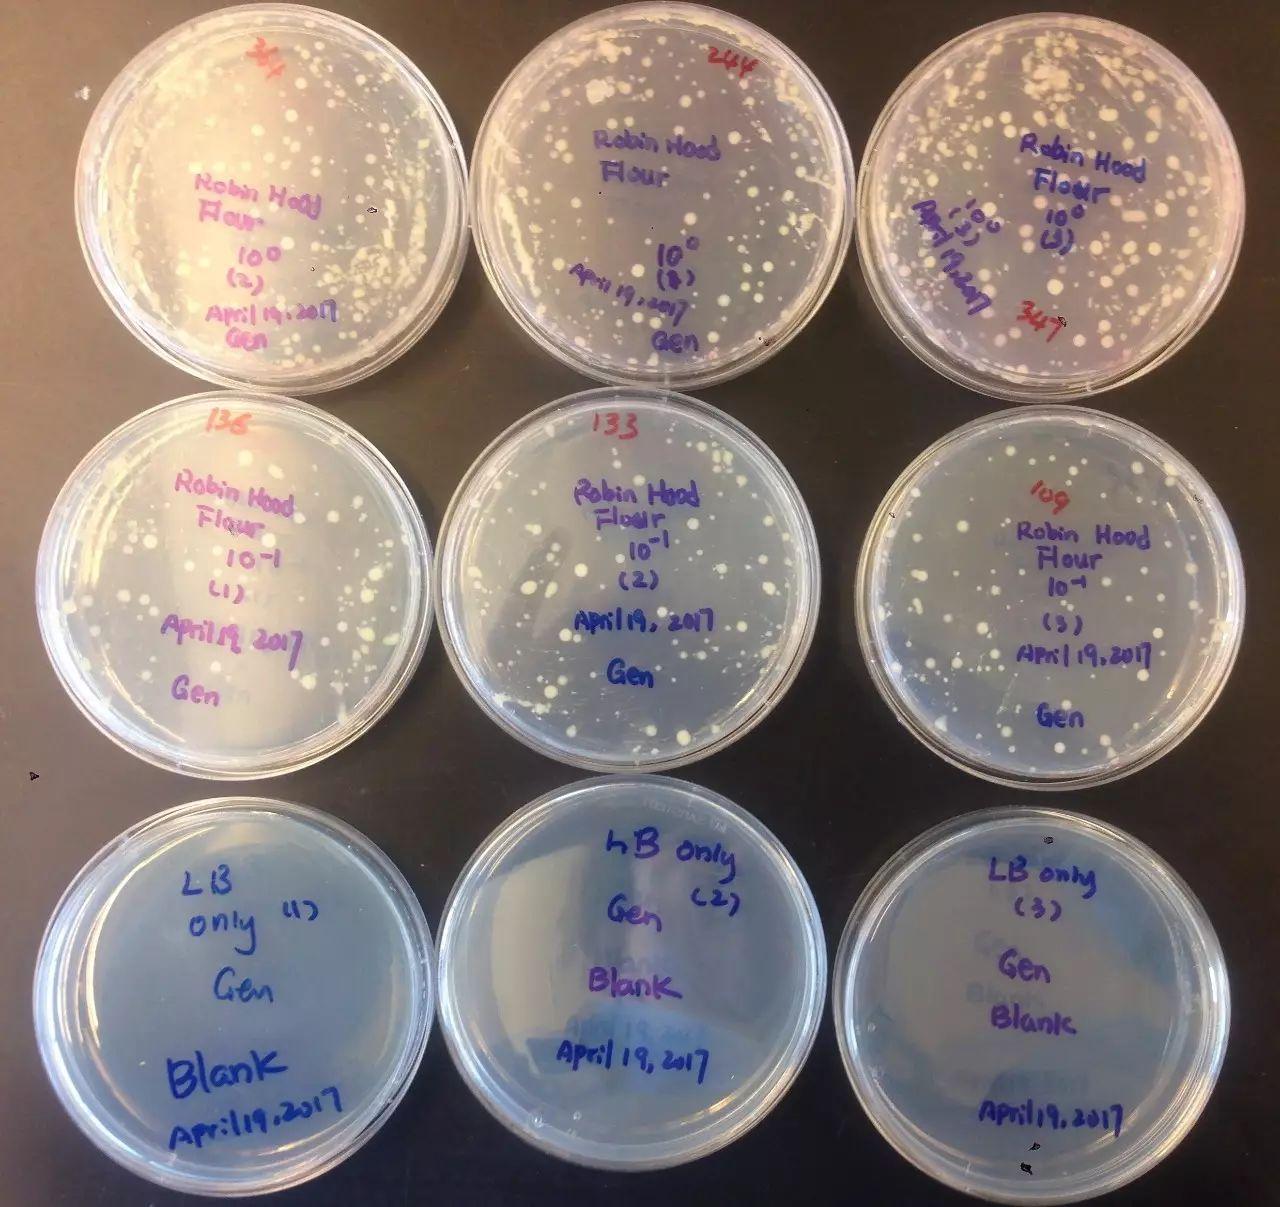
餐具消毒正确打开方式你知道吗?用臭氧水给餐具除菌消毒高效健康

餐具清洗不到位不干净,会残留一些细菌病毒,有致病性大肠杆菌、沙门氏菌、志贺氏菌、霍乱弧菌、蜡样芽孢杆菌等多种微生物。它们很可能会引发肠道传播性疾病,常引起急性腹泻。所以很多人非常重视餐具的消毒,一般家里面会用到的餐具消毒方式无外乎:消毒产品、沸水蒸煮、高温加热、消毒柜、洗碗机。

❶ 消毒产品:达到效果需看情况
这类产品主要分为有杀菌、抑菌效果的洗洁精,以及消毒泡腾片。前者从产品成份来看,描述都十分模糊,没有明显的杀菌、抑菌成份。总的来说,洗洁精破坏了细菌滋生的环境,但是如果你希冀于它能消灭细菌,可能就无法达成心愿了。
而消毒泡腾片,有一些是有效果的,不过它的浸泡时间如果时间不达标,灭菌效果就会大打折扣了。像餐饮行业里,用到消毒产品进行餐具消毒时,一般都会进行多次且长时间的浸泡。

❷ 蒸煮&高温加热:足够时间才有效
沸水蒸煮和高温加热对于杀菌都是有一定作用的,我们来一一看看可以灭菌的温度:温度越高所用时间越短,此处写出的灭菌温度多为灭菌最低温度。
所以简单的煮沸可以消灭很大一部分细菌,但是并不能绝对灭菌杀菌。而且一定要注意的是,煮沸的时间很关键。如果只是在餐厅里用滚烫的茶水快速地烫一下餐具,时间太短是起不到杀菌灭菌的作用的。另外,某些细菌对高热有更强的抵抗力,如炭疽芽孢、蜡样芽孢等。一般来说,5 分钟可以消灭一般的细菌,对于上述提及的就需要再多一点的时间啦,比较推荐每次煮沸 15-20 分钟。

❸ 洗碗机:有作用但效果不彻底
洗碗机可以一口气走完清洗、烘干以及消毒的流程,看起来超级方便有木有!但是深究起来,它的消毒效果和消毒柜相比略差一些些,毕竟术业有专攻嘛。那么它的效果到达哪种程度了呢?
现在市面上大部分洗碗机配置的消毒功能,一般是采用高温消毒的方式,温度在 70-80℃ 左右,这个温度可以杀死大部分细菌,不过像乙肝这类耐高温到 100℃ 的就没办法彻底杀死了。另外,水流的冲刷也可以带走一部分细菌,但是效果有限,而且前提是,水源没有被细菌污染。

❹ 消毒柜:效果好但是用后需注意维护
消毒柜作为专门消毒的电器,它的效果是毋庸置疑的,一般会有三种消毒方式:臭氧、紫外线以及高温。
臭氧:可以进入细菌、病毒的内部,作用于蛋白、RNA 等物质,破坏其组织达到彻底杀菌效果;
紫外线:可以破坏细菌、病毒的 DNA 结构,达到杀菌或破坏其繁殖的作用。
高温:通过加热达到杀菌温度。

这三种方式各有优劣,不过都能比较好地达到灭菌的效果。但是消毒柜使用的时候也有着一些注意事项,比如完成消毒工作后要将内部积水擦干,或是打开门,否则消毒柜内部照样会发霉不误。

以上四种餐具消毒方式或多或少有各种缺陷,消毒产品可能会有化学残留,高温消毒对餐具材质有要求,塑胶材质就不可高温,易散发出有毒的有害物质。如果把金属餐具放入烤箱或微波炉进行高温消毒,那就有爆炸危险,需要特别注意。洗碗机本身清洗不到位,对餐具会造成二次污染,而消毒柜后期维护成本高昂。

综上所述,这些消毒方式各有不足,那么有什么更好的消毒方式吗?臭氧水消毒就是效果很好的餐具消毒的解决方案。

臭氧的氧化性很强,臭氧可以氧化分解细菌等微生物内葡萄糖所必需的酶,也可以直接与细菌、病毒发生作用,破坏其细胞和核糖核酸,分解DNA、RNA、蛋白质、脂质类和多糖等大分子聚合物,使细菌等微生物内的物质发生通透性畸变,导致细胞的溶解死亡,可杀灭细菌繁殖体、病毒、真菌、霉菌、大肠杆菌、金黄色葡萄球菌等等,同时,臭氧还可以杀灭肝炎病毒、感冒病毒等,这样消毒就比较全面了。
臭氧溶于水,生成臭氧水,同样具有极强杀菌的氧化性。用臭氧水对菌悬液进行消毒,定量培养,计算杀菌率.结果在5 mg/L浓度下对标准菌株大肠埃希菌,金黄色葡萄球菌,白色念珠菌作用1 min杀灭率可达100%,对枯草杆菌芽胞作用10 min杀灭率可达99.99%;用临床菌株试验,在5 mg/L浓度下作用0.5 min,对金黄色葡萄球菌,大肠埃希菌,白色念珠菌的杀灭率为100%,在1.25 mg/L浓度对金黄色葡萄球菌,大肠埃希菌,白色念珠菌,铜绿假单胞菌的杀灭率均>99.3%.可以看出,臭氧水具有快速,高效杀菌作用。

因此,使用臭氧水用于餐具的清洗浸泡消毒除菌,相比于以上几种方式,优势非常明显。臭氧活水机一次安装,持久耐用便捷,利用水压发电生成臭氧,臭氧与自来水交溶生成臭氧水,直接用来餐具消毒,非常方便简单。臭氧水除了强大的除菌消毒作用,还能降解农药残留,去除臭味及脚气,在家庭中用于衣物、果蔬及其他物品的清洗除菌消毒,还能用于个人的卫生,比如使用臭氧水洗澡、洗脚、洗脸,保养皮肤,预防皮肤疾病。

最后要说的是,细菌病毒无处不在,病从口入,共餐制的我们容易引发交叉感染,对餐具的消毒除菌必要引起重视。清洗餐具不能仅仅看起来干净就完事了,除菌消毒工作不容松懈,否则就是对自己和家人的健康的不负责任。臭氧水多种用途,非常适合在家庭中推广使用,为健康保驾护航。